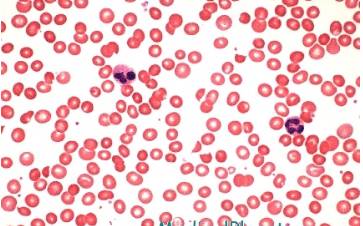

Содержание
- Какими анализами проверяется?
- Что может повлиять на результаты анализа?
- Какие значения для детей считаются нормой?
- Как меняются значения в зависимости от возраста?
- Нормы для недоношенных
- Какие значения считаются повышенными и о чем это говорит?
- Какие значения – пониженные, и о чем это говорит?
- Когда состояние становится опасным?
- Как восстановить значения до нормы?
- Вопрос-ответ
- Советы
Наша кровь становится красной из-за сложного белка под названием «гемоглобин». Последний выполняет крайне важную функцию: находящееся в его составе железо связывается с кислородом или углекислым газом и транспортирует его в клетки (кислород) или в легкие (углекислый газ). Клетки нашего тела могут дышать благодаря гемоглобину. Именно поэтому показатели гемоглобина так важны при диагностике и мониторинге, и особенно это касается детей. Таблица нормы гемоглобина у ребенка от первых дней жизни и до подросткового возраста – это то, что знает наизусть каждый педиатр. Ниже мы объясним эти нормы и отклонения от них для тех, кто не имеет медицинского образования.
Какими анализами проверяется?

Анализ крови на hgb из вены берут редко: когда нужно опровергнуть или подтвердить повышенный уровень сахара в крови.
Поскольку ребёнку диагноз «сахарный диабет» ставят исключительно редко, детей на гемоглобин проверяют с помощью крови из пальца.
Врачи подчеркивают важность контроля уровня гемоглобина у детей, так как он играет ключевую роль в транспортировке кислорода к тканям и органам. Нормы гемоглобина варьируются в зависимости от возраста и пола ребенка. Например, у новорожденных уровень гемоглобина может достигать 22 г/дл, в то время как у детей старшего возраста нормальные значения колеблются от 11 до 16 г/дл. Врачи рекомендуют регулярно проводить анализы крови, особенно в период активного роста, чтобы своевременно выявить возможные отклонения. Низкий уровень гемоглобина может свидетельствовать о железодефицитной анемии, что требует немедленного внимания и коррекции питания. Важно, чтобы родители обращали внимание на симптомы, такие как усталость, бледность и снижение активности, и не откладывали визит к врачу.

Что может повлиять на результаты анализа?
Уровень гемоглобина у детей, как говорилось выше, крайне важен при обследованиях. Увы, получить достоверные данные о том, что происходит в крови, бывает непросто. Проблема здесь в том, что кровь – это очень сложная и динамичная ткань (только жидкая), которая связана со всеми системами организма, и небольшое изменение работы любой части тела может отразиться на качестве анализов. Среди самых частых причин изменения показателей гемоглобина в крови выделяют следующие:
- Еда. После плотного завтрака показатели ненадолго снижаются.
- Время суток. Физиологические ритмы настроены так, что у человека с нормальным режимом дня вечером показатели так же снижаются.
- Положение тела. Уровень гемоглобина у ребенка понижается, если сдавать кровь лёжа. Это связано с тем, что насыщенная кровь оттекает от конечностей ко внутренним органам.
- Ошибка лаборанта. Все показатели в крови из пальца снизятся, если при заборе материала слишком сильно давить на палец. Причина – в межклеточной жидкости, которая попадает в анализ и разбавляет собой кровь.
- Некоторые болезни. При диарее, например, наступает обезвоживание, при котором концентрация плазмы снижается, а концентрация гемоглобина, наоборот, растет.
Из вышеперечисленного можно сделать простой вывод: чтобы анализ был максимально точным, нужно сдавать кровь утром, натощак, сидя.
Какие значения для детей считаются нормой?
Подробный список норм для детей разного возраста будет предоставлен ниже, сейчас же есть смысл объяснить, почему у ребенка норма меняется с возрастом и почему это так важно.
Гемоглобин, как уже говорилось выше, выполняет важную функцию: позволяет клеткам тела получать кислород и, таким образом, осуществлять клеточное дыхание, не имея прямого доступа к кислороду. Клеточное дыхание позволяет клеткам жить, и, что не менее важно, расти и размножаться.
Значение этих функций сложно переоценить.
В эмбриональном периоде ребенок пользуется специальным видом гемоглобина, который предназначен именно для этого периода. В постэмбриональном периоде (сразу после рождения) организм грудничков начинает вырабатывать «нормальный» hgb, при этом эмбриональные клетки крови еще функционируют (хотя и начинают стремительно распадаться). Поэтому норма гемоглобина у новорожденных намного выше, чем у 3 месячного ребенка.
По достижении трёх месяцев жизни показатели более-менее стабилизируются, хотя незначительное снижение вплоть до 2-х лет считается нормальным. В три года концентрация гемоглобина в крови начинает повышаться, потому что растущее тело требует все больше и больше кислорода. Особенно это связано с ростом мышц, потому что они требуют себе все больше питания.
Такая тенденция сохраняется вплоть до 18 лет, после чего организм с большего оказывается сформированным, и показатели стабилизируются.
Посмотрите видео на эту тему
Нормы гемоглобина у детей — важный аспект здоровья, о котором часто говорят родители и медицинские работники. Многие родители беспокоятся о том, достаточно ли у их ребенка гемоглобина, особенно в период активного роста и развития. Врачи подчеркивают, что уровень гемоглобина может варьироваться в зависимости от возраста и пола ребенка. Например, у новорожденных нормы могут достигать 200 г/л, тогда как у детей старшего возраста этот показатель постепенно снижается до 120-140 г/л.
Некоторые родители отмечают, что их дети часто устают или жалуются на головокружение, что может быть связано с низким уровнем гемоглобина. В таких случаях врачи рекомендуют проводить анализы и, при необходимости, корректировать питание, добавляя продукты, богатые железом, такие как мясо, бобовые и зеленые овощи. Обсуждая нормы гемоглобина, важно помнить, что регулярные медицинские осмотры помогут своевременно выявить возможные проблемы и обеспечить здоровье ребенка.

Как меняются значения в зависимости от возраста?
Нормы гемоглобина у детей сильно разнятся по возрасту:
- Гемоглобин у грудного ребенка (несколько дней с момента рождения): 195. Возможные значения: 170-220.
- Норма гемоглобина у детей до месяца: 140. Допустимые значения: 100-180.
- Гемоглобин у ребенка в 3 месяца: 125. Возможные границы: 110-140.
- Гемоглобин у детей до полугода: 125. Допустимые значения: 110-140.
- Норма гемоглобина у детей до года: 122. Возможные значения: 110-135.
- Нормальные показатели в 2 года: 120. Допустимые значения: 110-130.
- Норма в 3 года: 122. Возможные границы: 110-130.
- Нормальные показатели для 4 лет, 5 лет: 125. Допустимые значения: 110-140.
- С 5 до 9 лет: 130. Возможные значения: 115-145.
- 9 лет – 12 лет: 135. Допустимые границы: 120-150.
Для подростков старше 12 лет показатели начинают разниться по полу.
12-15 лет:
- Мальчики: 142. Возможные значения: 120-165.
- Девочки: 132. Допустимые границы: 115-152.
15-18 лет:
- Мальчики: 140. Возможные границы: 120-160.
- Девочки: 140. Допустимые значения: 120-155.
Все показатели указаны в «г/л».
Нормы для недоношенных

Речь идет о 1-5 днях жизни, в первый месяц норма у доношенных и недоношенных детей более-менее выравнивается. У недоношенного ребенка в 1 год средние показатели будут абсолютно такими же, как и у обычного. Но стоит отметить, что «ранние» дети более подвержены анемии, о которой будет рассказано ниже.

Какие значения считаются повышенными и о чем это говорит?
- Полицитемия. Это – болезнь, при которой красные тельца вырабатываются в избыточных количествах. Нужно отметить, что эта патология не возникает сама: она указывает на различные болезни селезенки или красного костного мозга.
- Обезвоживание. Уже упоминалось выше, повышенные показатели в данном случае связаны с уменьшением объема плазмы.
- Сердечная или легочная недостаточность. Количество гемоглобина возрастает как реакция компенсации.
Из «нормальных» причин следует отметить интенсивную физическую нагрузку и проживание в горной местности. В обоих случаях показатели повышаются по естественным причинам.
Диагноз «повышенный гемоглобин» малышу или подростку ставят редко, понижение встречается намного чаще.
Какие значения – пониженные, и о чем это говорит?
Большинство проблем с гемоглобином как у новорожденных детей, так и у подростков связано с его понижением. Причины:
- большая кровопотеря;
- инфекции;
- опухоли;
- побочный эффект от лекарств;
- анемия.
Последний пункт особенно важен, так как встречается чаще всего.

Когда состояние становится опасным?
Это зависит от того, что следует понимать под опасностью. Любое значение, выходящее за рамки допустимого, уже указывает на патологию. Отклонение от допустимого на 20 единиц (для младенцев, детей в год, 3 и 6 месяцев – 30) указывает на легкое заболевание, при котором опасность есть, но еще минимальна.
При большем отклонении появляется ощутимая угроза для здоровья или даже жизни.
Как восстановить значения до нормы?
Методы:
- специальная диета;
- правильная тактика грудного вскармливания;
- препараты, повышающие или понижающие гемоглобин;
- своевременное лечение болезней.
Гемоглобин – важный показатель, от которого зависит будущее развитие ребенка.
Красные кровяные тельца переносят кислород, который нужен клеткам для успешного функционирования. Нормальные значения гемоглобина у детей сильно зависят от возраста, что обязательно нужно учитывать при попытке расшифровки анализов.
Вопрос-ответ
Какая норма гемоглобина у детей?
При определении нормы уровня гемоглобина имеет значение возраст ребенка. Например, у новорожденного уровень гемоглобина 130 г/л и выше – это норма. Для 3-месячного ребенка нормой будет 100 г/л и выше. У ребенка 1–3 лет нормой считается 110 г/л и выше, 4–12 лет – 115 г/л и выше, 12–16 лет – 120 г/л и выше.
Как узнать гемоглобин у ребенка?
Анализ на гемоглобин у ребенка – это важное исследование, которое позволяет выявить нарушения в работе организма на ранних стадиях. Кровь берется из вены или из пальца. Перед сдачей анализа нужно соблюдать диету (исключить жареные и копченые блюда, сладкое). Кровь сдается натощак, утром.
Как ведут себя дети с низким гемоглобином?
Вялость, сонливость, плаксивость и раздражительность, плохой сон и быстрая утомляемость — типичные признаки анемии у детей. Железодефицитная анемия у детей сказывается и на работе пищеварительной системы. Нехватка железа может проявляться тошнотой и рвотой, диареей или запорами, пониженным аппетитом.
Советы
СОВЕТ №1
Регулярно проверяйте уровень гемоглобина у вашего ребенка. Это можно сделать во время плановых медицинских осмотров или при наличии симптомов, таких как усталость, бледность или головокружение. Раннее выявление отклонений поможет избежать серьезных проблем со здоровьем.
СОВЕТ №2
Обратите внимание на питание вашего ребенка. Убедитесь, что в его рационе присутствуют продукты, богатые железом, такие как мясо, рыба, бобовые, орехи и зеленые листовые овощи. Также важно включать в меню источники витамина C, который помогает усваивать железо.
СОВЕТ №3
Следите за симптомами анемии. Если вы заметили у ребенка частые головные боли, слабость или снижение активности, обратитесь к врачу. Эти симптомы могут указывать на низкий уровень гемоглобина и требуют медицинского вмешательства.
СОВЕТ №4
Обсуждайте результаты анализов с педиатром. Если уровень гемоглобина вашего ребенка ниже нормы, врач может рекомендовать дополнительные исследования или изменения в рационе. Не стесняйтесь задавать вопросы и уточнять все детали, чтобы лучше понять состояние здоровья вашего ребенка.


